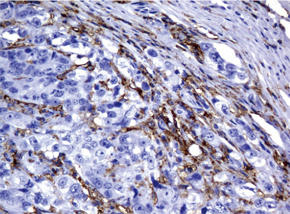

FCGR2A を特異的に検出する「UltraMAB® 抗体」です。免疫組織染色(IHC)に最適です
背景
FCGR2A / NM_021642
FCGR2A遺伝子は、数々の免疫応答細胞表面に存在する免疫グロブリンFc 受容体遺伝子ファミリーメンバーのひとつをコードする。FCGR2Aタンパク質はマクロファージや好中球といった食作用性細胞上に存在する細胞表面受容体で、貪食や免疫複合体の排除といったプロセスに関与する。複数の選択的スプライシングバリアントが同定されている[RefSeq Oct 2008]。
製品データ
![]() |
![]() |
| 図.1 パラフィン包埋したヒト乳房組織をanti-FCGR2A マウスモノクローナル抗体を使って免疫組織化学染色 左:Clone UMAB59、右:Clone UMAB60 |
|
![]() |
![]() |
| 図.2 パラフィン包埋したヒト乳房組織の腺がんをanti-FCGR2A マウスモノクローナル抗体を使って免疫組織化学染色 左:Clone UMAB59、右:Clone UMAB60 |
|
![]() |
![]() |
| 図.3 パラフィン包埋したヒト結腸組織をanti-FCGR2A マウスモノクローナル抗体を使って免疫組織化学染色 左:Clone UMAB59、右:Clone UMAB60 |
|
![]() |
![]() |
| 図.4 パラフィン包埋したヒト結腸組織の腺がんをanti-FCGR2A マウスモノクローナル抗体を使って免疫組織化学染色 左:Clone UMAB59、右:Clone UMAB60 |
|
![]() |
![]() |
| 図.5 パラフィン包埋したヒト肺組織をanti-FCGR2A マウスモノクローナル抗体を使って免疫組織化学染色 左:Clone UMAB59、右:Clone UMAB60 |
|
![]() |
![]() |
| 図.6 パラフィン包埋したヒト肺組織の細胞腫をanti-FCGR2A マウスモノクローナル抗体を使って免疫組織化学染色 左:Clone UMAB59、右:Clone UMAB60 |
|
詳細情報
| 遺伝子名 | Homo sapiens Fc fragment of IgG, low affinity IIa, receptor (CD32) (FCGR2A), transcript variant 2 | ||||||
|---|---|---|---|---|---|---|---|
| 別名 | CD32; CD32A; CDw32; FCG2; FcGR; FCGR2; FCGR2A1; IGFR2 | ||||||
| 抗原 | Full length human recombinant protein of human FCGR2A (NP_067674) produced in HEK293T cell. | ||||||
| バッファー | PBS (PH 7.3) containing 1% BSA, 50% glycerol and 0.02% sodium azide. | ||||||
| クローン | UMAB59 UMAB60 |
適用 | IHC, 10K-CHIP IHC, 10K-CHIP |
アイソ タイプ |
IgG1 IgG1 |
推奨 希釈条件 |
IHC 1:100~150, IHC 1:100, |
| 交差種 | Human | 濃度 | 0.5〜1.0 mg/ml (Lot Dependent) | ||||
| 精製 | Purified from mouse ascites fluids by affinity chromatography (Protein A or G Sepharose) | ||||||
FCGR2A / NM_021642 UltraMAB® 抗体
| 品名 | メーカー | 品番 | 包装 | 希望販売価格 |
|---|---|---|---|---|
Anti CD32A (FCGR2A), Human (Mouse) , UMAB59![]() |
ORG | UM570050 | 30 UL [0.77mg/ml] |
¥75,000 |
Anti CD32A (FCGR2A), Human (Mouse) , UMAB59![]() |
ORG | UM500050 | 100 UL [0.77mg/ml] |
¥204,000 |
Anti CD32A (FCGR2A), Human (Mouse) , UMAB60![]() |
ORG | UM570051 | 30 UL [0.70mg/ml] |
¥75,000 |
Anti CD32A (FCGR2A), Human (Mouse) , UMAB60![]() |
ORG | UM500051 | 100 UL [0.70mg/ml] |
¥204,000 |
商品は「研究用試薬」です。人や動物の医療用・臨床診断用・食品用としては使用しないように、十分ご注意ください。
※ 表示価格について






















このページを印刷する